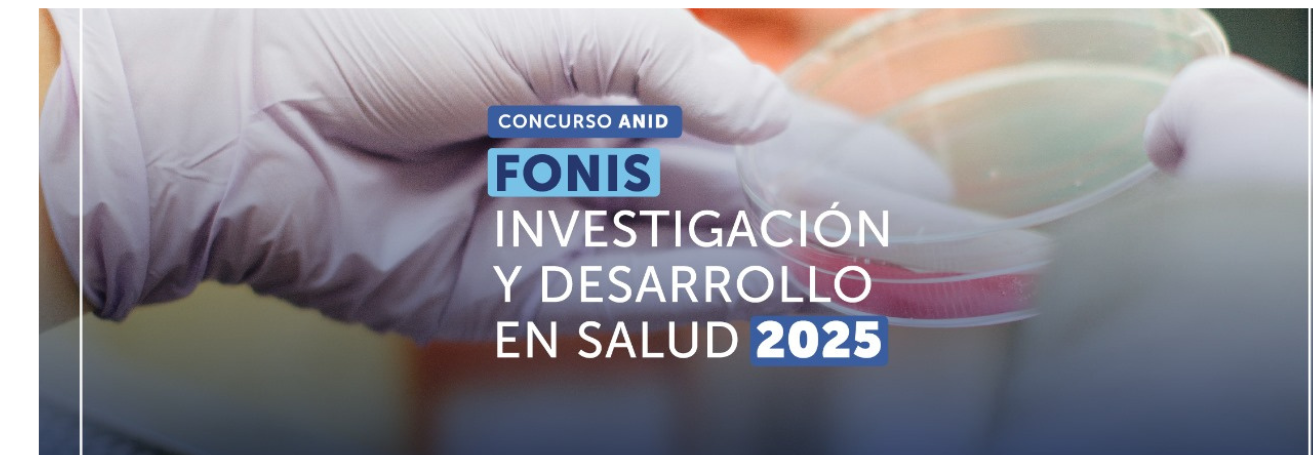

El Departamento de Desarrollo e Innovación (DDI), de la Vicerrectoría de Investigación, Desarrollo y Creación Artística (VIDCA) de la Universidad Austral de Chile, informa que a partir del 16 de enero de 2025 se encuentra abierto el Concurso de Investigación y Desarrollo en Salud, FONIS 2025, cuya fecha de cierre será el jueves 24 de abril de 2025, a las 17:00 hrs. de Chile continental.
Objetivo del concurso:
Generar y difundir conocimiento, a través de proyectos de investigación científica y tecnológica aplicada que contribuyan a la resolución de los problemas prioritarios que se asocian a los objetivos sanitarios vigentes.
Duración: Hasta 24 meses.
Financiamiento y entidades participantes:
- El subsidio de ANID será de un máximo de $70.000.000.
- La (s) Entidad (s) Beneficiaria (as) deberá (n) comprometer al menos un 10% del monto solicitado como subsidio a ANID. Este aporte podrá ser incremental o no incremental.
- En caso que existan entidades Beneficiarias Secundarias, se deberá disponer de al menos un 20% del subsidio ANID para cada una de ellas.
- Opcionalmente podrán participar entidades Colaboradoras (máximo de cinco) quienes ponen a disposición capacidades y know how para facilitar su ejecución.
- Se valorará en la evaluación la participación de entidades que reconozcan y den valor a la problemática planteada por el postulante.
- Las entidades colaboradoras no podrán recibir aportes del subsidio para la coejecución de actividades del proyecto.
- Las entidades colaboradoras no podrán se subcontratadas por alguna de las beneficiarias del proyecto.
Postulación
Para manifestar la intención a postular de este llamado, deberá completar y enviar el perfil I+D+i en el siguiente enlace.
A los equipos interesados en postular, se solicita remitirse al siguiente calendario interno:
| Actividad | Responsable | Fecha |
| Envío de perfiles por plataforma online enlace | Equipo de investigación | Hasta el viernes 21 de marzo de 2025, 18.00 hrs. |
| Reunión preliminar obligatoria con equipos de investigación, Dirección de Infraestructura y Servicios, Departamento de Desarrollo e Innovación VIDCA y OTL para la presentación de iniciativas en formato ppt del Concurso. | Equipo de investigación | 25 y 26 de marzo de 2025. |
| Asignación de Ejecutivos Departamento de Desarrollo e Innovación. | Departamento de Desarrollo e Innovación VIDCA | 27 de marzo de 2025. |
| Programación de trabajo en conjunto con equipos de investigación UACh (con ficha de perfil enviada) | ||
| Acompañamiento en la formulación de iniciativa. | Equipo de investigación y ejecutivos DDI. | Desde el 27 de marzo de 2025 hasta el 22 de abril de 2025. |
| Estructuración de presupuesto para envío a Departamento de Gestión Financiera de Proyectos (VGEA). | Departamento de Desarrollo e Innovación VIDCA | Desde el 27 de marzo de 2025 hasta el 10 de abril 2025. |
| Firma macrounidades Cartas compromiso internas por horas de investigadores comprometidas, uso de equipamiento preexistentey espacios físicos. | Equipo de investigación | Hasta el 10 de abril de 2025. |
| Proceso de firma institucional recepción de cartas de compromiso institucional validadas por macrounidad correspondiente. | Equipo de investigación | Hasta el 11 de abril de 2025. |
| Cierre Concurso Ingreso y envío de postulación vía plataforma | Director de proyecto | 24 de abril de 2025, 17:00 hrs. Chile continental |
Para más detalles sobre el proceso de acompañamiento y consultas dirigirse a miguelcarcamo@uach.cl, adiaza@uach.cl, cristopher.toledo@uach.cl, ignacio.viveroscarrasco@uach.cl.